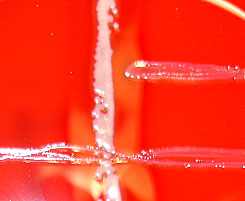
Camp test positif

>
Amplification ou inhibition de l’hémolysine de Staphylococcus aureus en présence de certaines espèces bactériennes.
Réalisation :
Gélose au sang, strie de S. aureus + strie perpendiculaire d’une autre espèce
Incubation à 37°C, 5%CO2
Lecture à 24-48h
Espèces camp-test positif : S. agalactiae, L.
monocytogenes …
Espèces
reverse CAMP-test : Arcanobacterium haemolyticum, Corynebacterium
ulcerans
Ex : Strie de S. agalactiae (horizontale) + strie de S. aureus (verticale) :